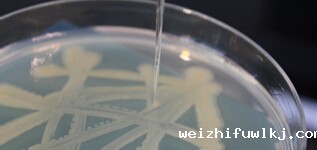

拜耳公司 |
同济大学 |
联合大学 |
美国保洁 |
美国强生 |
瑞士罗氏 |
粘度、稠度及表面张力的定义和应用实例
来源:本站原创 浏览 653 次 发布时间:2019-08-08
几乎每天我们都有关于粘度,稠度和表面张力之间差异的问题。通常有问题的第二部分;
“我们如何将这些不同属性的测量值联系起来?”
简单的答案是它们不同,它们以不同的方式测量,并且测量不能相关。
一个共同的要素是每个都是液态材料的属性。尝试在这些属性之间转换测量值导致破坏失败或卷积近似算法。
然而,这些测量中的每一个都对许多类型产品的配方开发,生产方法和最终质量具有显着影响。液体的这些属性在医疗保健,食品生产,涂料和药品等多种行业中至关重要。
将这些液体特性中的每一个都清晰地展示出来,并展示一些如何在每天产品中使用这些测量值的示例。
定义
粘度最简单的定义是测量液体流动的阻力。这种简单的定义因实际液体的现实而变得复杂。
有些人以合理的方式做出反应,并在很宽的速度范围内具有相同的阻力。
有些会随着速度而增加阻力,而其他则会随着速度而降
有些人随着时间的推移而改变阻力。
这产生了一些有趣的测量挑战。关于唯一的共同特征是所有粘度值随温度而变化。
一致性是与坚固性或厚度相关的属性。
该术语用于许多仅施加重力流动的材料。
观察在指定时间段内流动的程度或距离是这些测量的原理。
测量项通常是时间和距离的推导,并且无法转换为标准流变学术语。
与粘度一样,稠度随温度而变化。
表面张力,是最容易定义的概念。它是液体表面分子之间的吸引力。这种吸引力可以防止液体飞散到空气中并抵抗表面的渗透。
当表面张力降低时,液体更容易与其他材料混合。例如,洗涤剂降低水表面张力,这允许水渗透衣物纤维并冲洗掉污垢。
观察蜘蛛在水上行走并观察表面张力的影响。蜘蛛的腿不会穿透表面。
表面张力是接触角分析的基本特征。这是液体与固体表面或基底的相互作用。
这是受温度影响的另一种液体现象。
这些测量,粘度,稠度和表面张力中的每一个都有两个共同点。每个都是液体的属性,每个都受温度的影响。
以下是在常见产品的开发和生产中使用这些测量的一些示例。
行业应用
在涂料工业中,有几种产品特性可以通过这些液体特性来定义。
表面张力的影响直接与粘附特性有关。粘合剂在油墨和油漆的开发中很重要,因为它们必须设计成粘附在不同的表面上。
表面张力和相关的接触角分析是涂层和墨水与固体表面或基材的关联的关键。
粘度水平在开发涂料应用方法和系统中是至关重要的,因为该属性影响流动特性。
石油产品规格通常根据粘度来定义。
一个例子是机油名称,如10W/30-粘度参考。
粘度测量和比较用于监测润滑油的劣化。
表面张力测试用于检测变压器油等产品中的杂质。
食品生产对这些液体属性有很多应用。
表面张力是确定混合性特征的重要因素,例如为沙拉酱选择不同的液体组分。
粘度测量的价值在于番茄酱配方等产品的开发,以获得厚度和流动性的最佳组合。
许多番茄制品,调味品和芥末等调味品的加工质量控制标准是一种称为Bostwick Consistometer的稠度测量装置。
在药物世界,表面张力是在效力或药物递送系统的设计中的重要元素。例如:
开发最有效的粘合剂关系,如聚合物或淀粉到胶囊中的药物颗粒
开发复杂的液体机械结构,定义新的脂质体聚焦药物输送系统的释放条件
特殊的交付要求,如滴眼液。
这些开发活动转化为材料和生产控制应用,其中粘度测量通常是质量标准。
防水是产品开发严重依赖表面张力的一个例子。
用于防水帐篷织物的产品是基于织物编织中的空间尺寸与雨滴的附着力或表面张力的关系。
对于习惯露营的人来说,这些布料帐篷将开启雨水。
但是,如果您将手指按在液滴上,它会将其推过织物中的小开放空间。
血液粘度可能是与心脏危险因素相关的单一参数,例如:
高血压,高LDL,II型糖尿病和肥胖。
高血液粘度是这些因素将主要的炎症性损伤传递到动脉壁的主要机制。
血液粘度通常使用基于毛细管技术的自动扫描粘度计测量。
